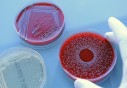

Traversée sur le Tariq Ibn Ziyad : L’ENTMV à la rescousse de la SNCM
Traversée sur le Tariq Ibn Ziyad : L’ENTMV à la rescousse de la SNCM
-
 Santé
18-02-2016 | 17:41
Santé
18-02-2016 | 17:41Zika: les cas de microcéphalie ont progressé de 10% au Brésil
-
 Santé
18-02-2016 | 17:28
Santé
18-02-2016 | 17:28Le transfert des technologies, une opportunité pour développer la santé en Afrique et sauver des vies
-
 Santé
18-02-2016 | 17:24
Santé
18-02-2016 | 17:24Inspection régionale du travail de l’Oranie : Pas moins de 10 pc de diabétiques parmi les travailleurs d’entreprises inspectées
-
Santé
17-02-2016 | 14:15
Santé
17-02-2016 | 14:15Leucémie: Entre 7 et 10 % des cas sont exposés aux infections fongiques invasives en milieu hospitalier (spécialiste)
-
 Santé
16-02-2016 | 19:19
Santé
16-02-2016 | 19:19Un patient opéré d'une tumeur cancéreuse cérébrale muni de lunettes 3D
-
 Santé
16-02-2016 | 14:44
Santé
16-02-2016 | 14:44Manger trop de poisson pendant la grossesse augmente le risque d'obésité chez le bébé (étude)
-
 Santé
13-02-2016 | 21:22
Santé
13-02-2016 | 21:22Trois nouveaux vaccins dans le calendrier national de vaccination dès avril 2016
-
 Santé
12-02-2016 | 16:40
Santé
12-02-2016 | 16:4022 joueurs algériens retenus
-
 Santé
11-02-2016 | 18:16
Santé
11-02-2016 | 18:16Canada : Les commotions cérébrales ne conduisent pas forcément à une dégénérescence neurologique
Flux RSS DKNEWS-DZ.COM

LES FLASH ACTU
TOUTES LES NEWS
-
Il sera bientôt possible de prévenir le diabète de type 1
En rendant le système immunitaire tolérant aux cellules productrices d'insuline au cours du développement embryonnaire, il serait possible d'éviter le développement du diabète de type 1...
-
Le bruit aurait un impact sur le tour de taille
La pollution sonore pourrait jouer sur le surpoids voire l'obésité. La faute au stress qui en découle, selon des chercheurs suédois.
-
Pourquoi on ne doit pas boire plus de 4 tasses de café par jour
Une consommation de plus de 400 milligrammes de caféine par jour serait nocive pour la santé, surtout chez les femmes enceintes et les moins de 18 ans.
-
Peut-on devenir dépendant à des médicaments sans ordonnance ?
La dépendance à certains médicaments est un fait connu. Antidépresseurs, somnifère font partie de ceux-là. Mais les médicaments sans ordonnance peuvent aussi avoir cet effet.
-
Dyspraxie : comment savoir si mon enfant en souffre ?
Handicap invisible, la dyspraxie est pourtant une pathologie lourde et handicapante au quotidien. Caractérisée par une altération de la capacité à exécuter de manière automatique des gestes, elle doit être prise en charge. Le point...
-
Les accidents de la vie courante sont 10 fois plus nombreux que ceux de la route
Les premiers résultats de l'enquête MAVIE menée par l'Inserm viennent d'être publiés. Au total, 10% des sondés ont déclaré avoir été victime d'un accident de la vie courante nécessitant des soins médicaux au cours de l'année écoulée, contre 1% pour..
-
Accidents domestiques astuces pour un domicile sans danger
Pour accueillir des enfants ou des personnes âgées, il est important de penser à quelques petits détails qui peuvent éviter bien des accidents. Le point avec le Docteur Christophe Trivalle, médecin gériatre.
-
Dermatologie : pensez à laver vos habits neufs !
Non, les habits neufs ne sont pas automatiquement propres ! Selon un chercheur américain, il faudrait impérativement les laver une première fois avant même de les porter pour éviter les troubles dermatologiques.
L'EDITO
Le Président de la République, Abdelaziz Bouteflika, a reçu hier le Premier ministre français, Jean-Marc Ayrault, en visite officielle en Algérie. L'audience s'est déroulée en présence du Premier ministre, Abdelmalek Sellal. Lors de cette audience...
LIRE LA SUITEPHOTOS & VIDEOS
-
LE FORUM 14-04-2014 | 15:41Mr Abdelaziz Belkhadem au Forum de DK News 14/04/2014
CHRONIQUES
-
 Walid B
Walid B
Grâce à des efforts inlassablement consentis et à une efficacité fièrement retrouvée, la diplomatie algérienne, sous l’impulsion de celui qui fut son artisan principal, en l’occurrence le président de la République Abdelaziz Bouteflika, occupe aujour
-
 Boualem Branki
Boualem Branki
La loi de finances 2016 n’est pas austère. Contrairement à ce qui a été pronostiqué par ‘’les experts’’, le dernier Conseil des ministres, présidé par le Président Bouteflika, a adopté en réalité une loi de finances qui prend en compte autant le ress
-
 Walid B
Walid B
C'est dans le contexte d'un large mouvement de réformes sécuritaires et politiques, lancé en 2011, avec la levée de l'état d'urgence et la mise en chantier de plusieurs lois à portée politique, que ce processus sera couronné prochainement par le proj
-
 Boualem Branki
Boualem Branki
La solidité des institutions algériennes, la valorisation des acquis sociaux et leur développement, tels ont été les grands messages livrés hier lundi à Bechar par le ministre de l'Intérieur et des Collectivités locales Nouredine Bédoui.
-
 DK NEWS
DK NEWS
Le gouvernement ne semble pas connaître de répit en cette période estivale. Les ministres sont tous sur le terrain pour préparer la rentrée sociale qui interviendra début septembre prochain.
-
 Walid B
Walid B
Dans un contexte géopolitique régional et international marqué par des bouleversements de toutes sortes et des défis multiples, la consolidation du front interne s'impose comme unique voie pour faire face à toutes les menaces internes..
-
 Walid B
Walid B
Après le Sud, le premier ministre Abdelmalek Sellal met le cap sur l'Ouest du pays où il est attendu aujourd'hui dans les wilayas d'Oran et de Mascara pour une visite de travail et d'inspection.









 MAMI : Au cœur d’une usine algérienne de production de boissons gazeuses et de jus algériens
MAMI : Au cœur d’une usine algérienne de production de boissons gazeuses et de jus algériens  Laiterie Soumam : Les secrets d’une réussite
Laiterie Soumam : Les secrets d’une réussite  Lutte contre la drogue : Signature d’un accord entre le ministère des Affaires religieuses et l’ONLDT
Lutte contre la drogue : Signature d’un accord entre le ministère des Affaires religieuses et l’ONLDT 

